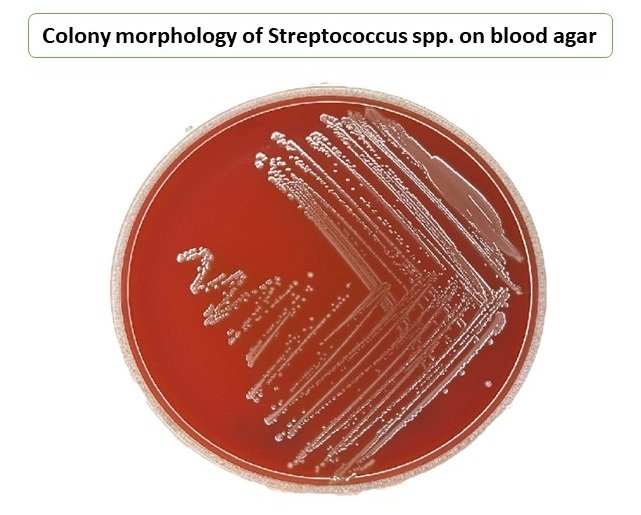
Colony morphology of Streptococcus spp. on blood agar
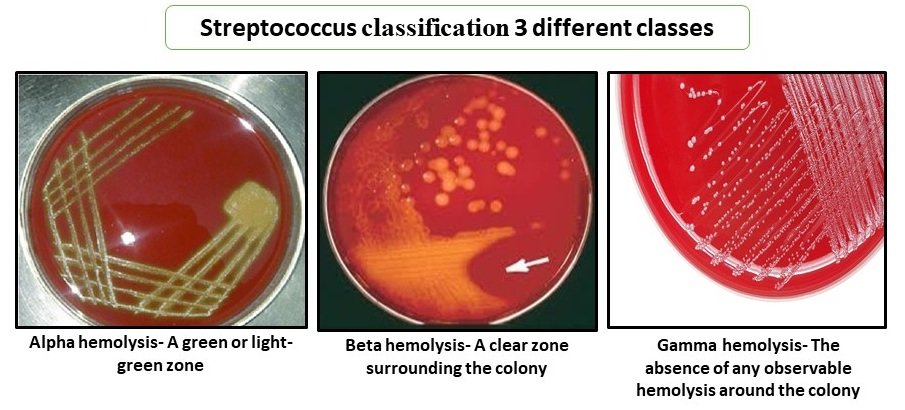
Streptococcus classification 3 different classes

Table of Contents
ToggleIntroduction to Streptococcus
The genus Streptococcus comprises a large and diverse group of Gram-positive cocci that are of major importance in medical microbiology, public health, and industry. Streptococci are widely distributed in nature and are commonly found as normal flora of the human oral cavity, upper respiratory tract, gastrointestinal tract, and genitourinary tract. While many species exist as harmless commensals, several are capable of causing mild to life-threatening infections in humans.
Diseases caused by streptococci range from pharyngitis and dental caries to severe systemic conditions such as rheumatic fever, post-streptococcal glomerulonephritis, septicemia, meningitis, necrotizing fasciitis, and pneumonia. Because of their clinical significance, streptococci remain one of the most extensively studied bacterial groups in microbiology.
Traditionally, streptococcal taxonomy in medical practice has relied on hemolytic patterns on blood agar and Lancefield serogrouping, rather than solely on species names. Among the most important human pathogens are Streptococcus pyogenes (Group A streptococcus) and Streptococcus pneumoniae (pneumococcus). In 1984, Group D streptococci were reclassified into a separate genus, Enterococcus, due to distinct genetic and physiological features.
Morphology of Streptococcus
Streptococcus species are Gram-positive, spherical or oval cocci measuring approximately 0.5–1.0 µm in diameter. Characteristically, the cells are arranged in chains or pairs, a feature that helps distinguish them from staphylococci, which appear in clusters.
Key morphological features include:
- Non-motile
- Non-spore forming
- Absence of flagella
- Catalase-negative
Certain species, particularly Streptococcus pneumoniae, possess a polysaccharide capsule, which is a major virulence factor. The capsule inhibits phagocytosis and enhances survival within the host, thereby increasing pathogenicity.

Colony Morphology on Blood Agar
Blood agar is the primary culture medium used for the isolation and identification of streptococci. Colonies typically appear as:
- Small to medium-sized
- Grayish-white or translucent
- Smooth or glossy
- Sometimes mucoid (especially capsulated strains)
The most distinguishing feature on blood agar is the type of hemolysis produced by streptococci, which forms the basis for their primary classification.
Cultural Characteristics of Streptococcus
The growth characteristics of Streptococcus species are summarized as follows:
- Growth occurs under aerobic and facultative anaerobic conditions.
- Optimal temperature: 37 °C.
- Group D streptococci can grow between 10–45 °C.
- Growth is enhanced in blood-enriched and sugar-containing media.
- Growth is generally poor on simple media.
- 5–10% CO₂ enhances growth and hemolysis.
- Selective media containing crystal violet (1:500,000) or aminoglycosides suppress competing flora.
- Colonies are usually colorless on blood agar.
Classification of Streptococcus
Streptococci are classified using three major approaches:
- Alpha (α) Hemolytic Streptococci
- Beta (β) Hemolytic Streptococci
- Gamma (γ) Hemolytic Streptococci
Alpha (α) Hemolytic Streptococci
- These bacteria cause incomplete hemolysis on blood agar, resulting in a greenish tint around the colony due to the reduction of red blood cell haemoglobin.
- This group includes Streptococcus pneumoniae (pneumonia) and Streptococcus viridans (oral streptococci), which are found in the normal flora of the respiratory tract and oral cavity but can cause illnesses in certain people.
- Other alpha hemolytic streptococci, such as Streptococcus mutans, play an important role in dental caries.
Beta (β) Hemolytic Streptococci
- These microorganisms produce full hemolysis of red blood cells on a blood agar plate, resulting in a clear zone around the colony.
- The most common beta hemolytic groups are Group A (e. g., Streptococcus pyogenes) and Group B (e. g., Streptococcus agalactiae).
- Group A is known to cause strep throat as well as other skin illnesses.
- Group B is a major cause of neonatal infections and can also cause urinary tract infections and other diseases in adults.
- Other beta hemolytic groups, such as C, G, and F, may cause less frequent illnesses.
Gamma (γ) Hemolytic Streptococci
- No hemolysis.
- Often part of normal flora.
- Includes some Enterococcus species.
Important Species of Streptococcus
1. Streptococcus pyogenes (Group A Streptococcus)
General Characteristics
Streptococcus pyogenes is a strict human pathogen and one of the most clinically significant streptococcal species. It causes a wide spectrum of diseases ranging from mild infections to severe invasive conditions.
It is:
- Gram-positive
- Catalase-negative
- Beta-hemolytic
- Facultative anaerobe
- Lancefield Group A
Culture Characteristics
- Optimal growth at 37 °C.
- Requires enriched media containing blood or serum.
- Produces small, translucent colonies on blood agar.
- Surrounded by a wide zone of beta hemolysis.
- Virulent strains may form mucoid colonies due to capsule production.
Diseases Caused by S. pyogenes
- Pharyngitis (strep throat)
- Scarlet fever
- Impetigo, cellulitis, erysipelas
- Necrotizing fasciitis
- Streptococcal toxic shock syndrome
- Acute rheumatic fever
- Post-streptococcal glomerulonephritis
Biochemical Characteristics
| Test Name | Result |
| Catalase | Negative |
| Bacitracin sensitivity | Positive |
| PYR test | Positive |
| CAMP test | Negative |
| Motility | Negative |
| Urease | Negative |
| Mannitol fermentation | Positive |
Treatment
- Penicillin remains the drug of choice.
- Amoxicillin preferred in children.
- Macrolides (erythromycin, clindamycin) used in penicillin-allergic patients.
- Severe infections require IV penicillin + clindamycin and surgical intervention.
Diagnosis
- Throat swab with Rapid Antigen Detection Test (RADT).
- Blood agar culture showing beta hemolysis.
- ASO titer and anti-DNase B tests for post-streptococcal complications.
- PCR and blood cultures in invasive disease.
2. Streptococcus pneumoniae
General Characteristics
Streptococcus pneumoniae is a leading cause of community-acquired pneumonia and other invasive infections. It is a commensal of the nasopharynx but becomes pathogenic under favorable conditions.
- Gram-positive
- Alpha-hemolytic
- Lancet-shaped diplococci
- Encapsulated
- Optochin sensitive (important diagnostic feature)
Diseases Caused
- Pneumonia
- Otitis media
- Sinusitis
- Meningitis
- Septicemia
Pathogenesis
The polysaccharide capsule is the primary virulence factor. It prevents phagocytosis and allows survival in host tissues. Additional pathogenic mechanisms include:
- Adherence to respiratory epithelium.
- Autolysin-mediated inflammation.
- Cytokine and complement activation.
Biochemical Characteristics
| Test | Result |
| Catalase | Negative |
| Motility | Negative |
| Oxidase | Negative |
Treatment
- Penicillin and cephalosporins (if sensitive).
- Macrolides or fluoroquinolones in resistant strains.
- Antibiotic susceptibility testing is essential.
Diagnosis
- Blood agar culture showing alpha hemolysis.
- Urinary antigen detection.
- PCR-based molecular tests.
- CSF examination in meningitis cases.
Prevention
- Pneumococcal vaccination (PCV, PPSV).
- Respiratory hygiene.
- Hand hygiene.
- Prevention of secondary infections during influenza outbreaks.
Conclusion
Streptococcus is one of the most significant genera of Gram-positive bacteria in medical microbiology. These organisms are widely distributed in nature and commonly exist as part of the normal flora of the human body, particularly in the oral cavity, respiratory tract, gastrointestinal tract, and genitourinary tract. However, several species possess important virulence factors that enable them to cause a wide range of diseases, from mild localized infections to severe systemic and life-threatening conditions.
The identification and classification of streptococci are primarily based on their hemolytic patterns on blood agar and Lancefield serogrouping, which remain essential tools in clinical microbiology laboratories. Among the various species, Streptococcus pyogenes and Streptococcus pneumoniae are of major clinical importance due to their role in diseases such as pharyngitis, pneumonia, meningitis, rheumatic fever, and post-streptococcal complications.
Accurate laboratory diagnosis, timely antimicrobial therapy, and preventive strategies such as vaccination and proper hygiene practices are crucial in controlling streptococcal infections. Continued research on the pathogenic mechanisms and antimicrobial resistance patterns of streptococci is also essential to improve treatment outcomes and reduce the global burden of streptococcal diseases.
Frequently Asked Questions (FAQ)
Streptococcus species play a dual role in human health—as normal commensals and as serious pathogens. Their classification based on hemancefield grouping and hemolytic patterns remains crucial for laboratory diagnosis and clinical management. Among them, Streptococcus pyogenes and Streptococcus pneumoniae are of exceptional medical importance due to their association with invasive and post-infectious complications. Early diagnosis, appropriate antibiotic therapy, and effective vaccination strategies are key to reducing streptococcal disease burden worldwide.
Q1. Why is blood agar used for Streptococcus identification?
Blood agar helps identify streptococci based on their hemolytic patterns (alpha, beta, gamma), which is essential for classification and diagnosis.
Q2. What is the difference between alpha and beta hemolysis?
Alpha hemolysis causes partial RBC destruction with green discoloration, while beta hemolysis causes complete RBC lysis forming a clear zone.
Q3. Which Streptococcus species causes rheumatic fever?
Streptococcus pyogenes (Group A) is responsible for acute rheumatic fever following untreated pharyngitis.
Q4. What is the major virulence factor of Streptococcus pneumoniae?
The polysaccharide capsule, which prevents phagocytosis.
Q5. How is Streptococcus pyogenes differentiated in the lab?
By beta hemolysis, bacitracin sensitivity, and positive PYR test.
Reference and Sources
- https://www.ncbi.nlm.nih.gov/books/NBK554528/
- https://nios.ac.in/media/documents/dmlt/Microbiology/Lesson-15.pdf
- https://www.news-medical.net/health/Streptococcus-pneumoniae-(pneumococcus)-Overview.aspx
- https://microbiologynotes.org/blood-agar-composition-principle-preparation-and-uses/
Also Read:
- Difference Between Probiotics and Prebiotics
- Plasmids: Structure, Types, Replication, and Applications
- Microbiology: From Microorganisms to Career Opportunities
- Culture Staining Techniques in Microbiology: Types, Methods, and Applications
- Importance of Microbiology: Applications, Scope, and Benefits
- Rhizobium: The Nitrogen-Fixing Bacterium
- Detection of Viruses: Modern Methods, Applications, and Advancements
- Basic Microbiology Quiz
- Medical Microbiology Quiz
- Spirulina: The Superfood Microalga with Limitless Potential

